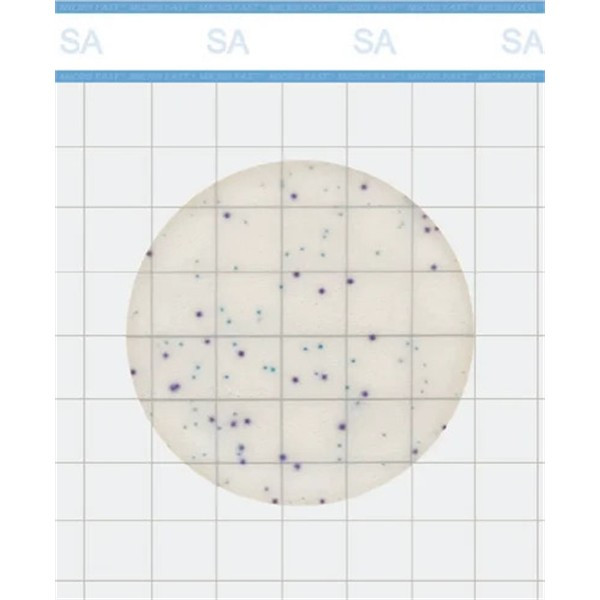
Staph Express Count Plate, Petrifilm, Neogen,

Description
MicroFast® Staphylococcus aureus Count Plate (SA) is a sample-ready-culture medium system. It uses innovative
technologies such as new-generation microbial coloration to achieve rapid proliferation and interpretation of colonies,
greatly improving the detection efficiency in the laboratory. Provides next day results.
The plate contains prefabricated type of medium, cold water gel and indicator. It is intended for the enumeration of
Staphylococcus aureus in food and environmental samples.